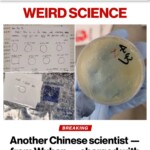

Curated Weekly Digest of Anon News
💃 Scroll to Bottom for Current Links & Memes; use Submenu for Previous Weeks 💃
June 10 – June 17 2025
Since the 1980s, six Globalist organizations have controlled the entire Mainstream Media (MSM) including network news, public news, magazines, books, movies & games.
Every way information can be spread, it has been controlled by the Globalists UNTIL Trump & Covid, when the worldwide Anon Army was activated, and Free Speech platforms sprang to life. Some are Authentic, much are Contrived; it’s up to each one of us to figure out what’s what.
In 2012, Obama passed the Smith-Mundt Modernization Act which (among other things) legalized propaganda within the borders of the US.

Your Information Source determines whether you consume truth… or propaganda.
We’ve been living in 5th Generational Warfare, an INFORMATION WAR – FOR OUR MINDS!!!
I’ve been an Anon since 1986; a college lecture laid out the New World Order, and I witnessed it all unfold over decades. I’ve been strongly influenced by two investigative journalists – my aunt Francie Bauer, an award-winning reporter, and another at the tip of the Globalist/CIA news syndicate. Both hounded me to pursue the Ultimate Seed of Truth – always dig deeper! I enjoy getting lost in the rabbit holes, but I try to honor that guidance and Find Truth if it can be found, and correct myself as knowledge evolves.
What I find over and over again is that Truth is Ever-Shifting, especially in this digital world. Part of the reason I’m presenting knowledge this way, is to have a record; a reference – so that I don’t have to rely on my own imperfect brain to recall details of what’s happening in our world.
Truth is different to different people.
Perhaps there is no ONE TRUTH.

There is a very serious RESET in progress
Redefining most aspects of our society
My newsfeed is curated according this Reset, along with my interests & hopes. It’s the product of my continual Self-Education across several different platforms, primarily Telegram, YouTube and Rumble. Plus, I have a few Thinkers I like to share, and we need Thinkers more than ever!!!
Caveat: I won’t post anything that I know to be fake, false or misleading (satire and opinion notwithstanding), and I’ll come back and clean up as knowledge evolves.
Take it or Leave it!!
Maybe you’ll be inspired to explore a few rabbit holes of your own.
NOTE: I am NOT giving financial advice, health advice or any other advice. I am recognizing that XRP will play a YUGE role in the next economy. Whether or not this next digital economy becomes totalitarian, or will be replaced by a more sovereign economy in the future, is yet to be known. Maybe the horse named Sovereignty winning 2 of the Triple Crown races means something….

It’s up to each one of us to secure FREEDOM – for ourselves and all future generations – by DEMANDING A BILL OF DIGITAL RIGHTS!!!
May your mind be ever-flexible
Snippets, source files, videos and more can be found on the @AquarianDotMe Telegram channel.
What’s What Current
Flying Cars Fast-tracked
WalMart funding national No King Protests on June 14
De-Dollarization in progress
Rogan w/ Dr. Mary Talley Bowden: McCullough was Right about EVERYTHING!
Tucker Carlson w/ Pavel Durov: Does Freedom Exist?
Al-Qaeda leader calls for the Assassination of President Trump and others
Marxist Roots of LA Mayor Bass
Marxist LA Mayor was the ring leader in the 1983 Capitol bombing
The ACIP meeting which caused the death of millions of Americans
ACIP Chair said ELIMINATE WHITE AMERICANS
RFK Jr. Eliminates Treasonous, Murderous Members of ACIP!!!!! 🌶️
RFK Jr. appoints actual scientists / doctors onto board of ACIP
Scenes from the LA Riots episode 2025
DARPA Gaming Out the next Plandemic
Media and Politicians describe LA Riots as Peaceful Demonstrations
Whistleblowers describe Sadistic Sexual Abuse in Israeli Jewish Ceremonies
Seattle’s Marxist Color Revolution underway
Maxine Waters: There’s NO violence!
NG empowered to arrest treasonous, violent Americans
What are the Akashic Records?
Gregg Braden: The Inner Portal to the Universe
Everything is unfolding according to the Q plan
The Clarity Act
Tucker Carlson w/ Jeffrey Sachs: Overview of global Socio-Political progress
The Evil Agenda
Government poisoned alcohol during Prohibition
The Dark Money Game documentary
Zelensky bought a multimillion dollar apartment for his mother in Dubai
SWIFT will use Digital Currencies via ISO20022 (activates July 14)
Washington state sues farmers for water rights
Jordan Peterson with Michael Saylor: Outsmarting Inflation
Homestead Festival 2025
State Attorneys General Warn: Big Beautiful Bill Will Strip States of Power Over AI
Rogan w/ Dr Bowden: COVID Patients Were EUTHANIZED to Free Up Beds
1990-2024 Crop Circle compilation
Bilderberg Meeting in Progress
LA Rioters face live ammunition
Palantir Technologies | World Economic Forum
Who’s Funding the Riots
Ally Carter speaks about Child Sex Trafficking
Timeline of Crypto regulation
Legal immigrants becoming MASSIVELY Conservative
Neville Singham: The man behind the LA Riots
Argentina economy experiencing fastest growth rate in global history
The enslavement system of student loans
Understanding Usury
The Rise of Peter Thiel – Emperor of Technocrats
Peter Thiel explains his anti-human plans
BRICS is on our side
Corbett / Broze: Opting out of Technocracy
Powerfully Nutritious & Useful Weeds
The Q Plan – coming to conclusion… 👀
60 Minutes Interview with Anonymous Mossad Agent
USAID execs found guilty in $500 Million Fraud
Whistleblower talks Epstein, Cannibalism, Slavery etc.
Rappoport: Who is Dr. Robert Malone?
Microneedle Nasal Delivery Device – Patent US20130085472A1
Trump ends California’s electric vehicle mandate
New Peer-Reviewed Study Documents Post-Vaccine Magnetism
FDA ends Universal Antidote suppression
Dark-Money funds ‘No Kings’ Color Revolution
Tenpenny: Profiting from the Problem & Solution
ChatGPT: How Technocracy profits from Chaos
Trump steps over the line with Iran
SK Lab creates 100% lethal Bird Flu
HHS: Universal Vaccine Platform
Did Smartmatic delete evidence?
Cabal aspects of the Hoover Dam
$500k Private Club for MAGA & Technocrats
The Trump Phone
Marxist Mayor Bass Threatens Continued Violence in LA
Small Farmers speak out about threat to their model
XRP valuation explained
Democrats universally call for violence
Gregg Braden: Humans are Advanced Technology
The All-powerful Jew(ish) Mafia
Foster Gamble: Powerful Alien Disclosure at the Pyramids
Another Pedophile Bust
NH “Right to Compute” Amendment
Colonel MacGregor Explains the Iran/Israel War
Russia launches Chinese-style super-app
US dollar Tanks
Spaniards rise up against Globalist leader
Mysterious radio waves in Antarctica
Army swears in technocrats as lieutenant colonels
Interview with Dr. Robert Malone
Gregg Braden: Torah Prophecy and the Great Reset ⚡️⚡️⚡️
Cestui Que Trust Act of 1666
Martin Armstrong: How the World Really Works ⭐️
Carlson/Greenwald: Zionist Audacity (short)
Bilderberg 2025: AI, Depopulation, Migration on the docket
Q Drop 35: POTUS telling us how The Plan would end
Sachs: Mossad runs the WHOLE show
Japan releases explosive vaccine re: health of vax vs unvaxxed
Vandersteele: Human trafficking goal exposed
Reza Pahlavi – son of the old Shah – speaks (not a shah, not a king)
Chinese plot to create fake mail-in ballots in 2020
PBD: US of Palantir
Tucker/Bannon: Is Israel destroying MAGA?
Zang: How to stay financial empowered
MacGregor: Keep America First
VAIDS Is Surging
Patent for remote contact tracing of vaccinated
Kamala’s California Communist Tyranny
The Tartarian Empire
Forever chemicals impacting FERTILITY in 98% of UK rivers
Note: This will be my final posting. I will retain my Telegram channel newsfeed. @AquariandotMe